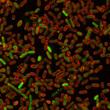
Green fluorescent spots form when DNA replication is stalled in membrane stained (red) E. coli cells. Stalling DNA replication is one way that DNA can be damaged by endogenous proteins in cells acting like carcinogens.

Join us in developing and applying new technologies and innovative methods to deepen understanding of biochemistry, biophysics and structural biology in human health and disease.
About the Program
As a graduate of our program, you will be equipped with cutting-edge technology skills and depth of knowledge required to investigate emerging fundamental and disease-associated questions in biology. While a student in the Chemical, Physical & Structural Biology Graduate Program, you will have access to multidisciplinary training opportunities including biophysical and biochemical analysis of proteins, biochemistry, pharmacology, chemical synthesis, combinatorial chemistry, structural biology, and protein design and engineering.

Diverse Perspectives
Our most essential strength is our community of highly collaborative scientists focused on the success of our science and our students. Our program draws together faculty members with shared interests to provide a diversity of scientific perspectives.

Where Will Your Ph.D. Take You?
From day one we encourage you to think deeply about your career choices. Wherever your ambition leads, you will receive the support you need to follow a path well worn by our alumni who have built successful careers across diverse endeavors.
CPSB Research News
To get a detailed picture of the cellular processes that differentiate normal versus cancer cells, researchers resort to conduct several independent screening assays at the expense of time and additional cost. In this study, the goal of the BCM researchers was to measure multiple cellular pathways at once in a single biological sample, which would also minimize experimental errors resulting from conducting multiple separate assays using different samples.
After eluding researchers for more than 30 years, the VP3 protein of rotavirus has finally revealed its unique structure and function to a team led by researchers at Baylor College of Medicine. The researchers knew that VP3 was necessary for capping messenger-RNA (mRNA), a process essential for the synthesis of viral proteins and for evading the host’s immune response, but while the structure and function of the other rotavirus proteins had progressively been unveiled, VP3 remained the last unsolved rotavirus mystery.
Baylor researchers discovered a new major class of cancer-promoting genes by showing that many normal proteins made by our cells can act like carcinogens, damaged DNA and causing mutations. Former graduate student and current postdoctoral associate at Baylor, Dr. Jun Xia was one of the two co-first authors on this study.
Single-celled bodies of the social amoeba Dictyostelium discoideum live in the soil voraciously feeding on bacteria. As this food source dwindles, the amoebas get stressed and respond by getting together, forming first a slug and then a fruiting body consisting of a ball of spores balanced atop a dead stalk. It’s been known for a number of years that the multicellular slug and the fruiting body stages of some, but not all, social amoeba carry bacteria. BCM researchers are investigating how some amoebas manage to maintain their own microbiome and, at the same time, keep an innate defense mechanism that should kill the bacteria.
Researchers use cryo-electron tomography to visualize macromolecules frozen in action and details of structures inside of cells. However, as a manual process, this was very time-consuming. A new method developed by Baylor researchers requires less human participation.
Subscribe now to From the Labs to stay up to date on the latest news from our researchers.
"I decided to take a pay cut and leave industry to be a CPSB graduate student because I knew the training I would get here at BCM would be invaluable in advancing my career."
Graduate School of Biomedical Sciences
The Chemical, Physical & Structural Biology Graduate Program is part of the Baylor College of Medicine Graduate School of Biomedical Sciences. Visit the GSBS website for information about our curriculum and admissions process as well as to find resources and services designed to support your success throughout graduate school and your future career.
Stipends and Benefits
Our students receive a competitive stipend, a tuition remission, and individual health insurance at no cost to the student. At BCM, your stipend and benefits are not linked with teaching obligations. We are focused on you and your training. If your vision for your future includes teaching, you may choose to gain experience as a teaching assistant. If you do not want to teach, you have the freedom to focus exclusively on your education and research as well as to work with your mentor to take advantage of other BCM resources that match your interests.

Supporting Your Success
From our extensive research resources, including advanced technology core labs and numerous collaborative research centers, to academic and support services, which include career development and physical and mental wellness services, we are committed to providing the resources and services you need to realize your goals.